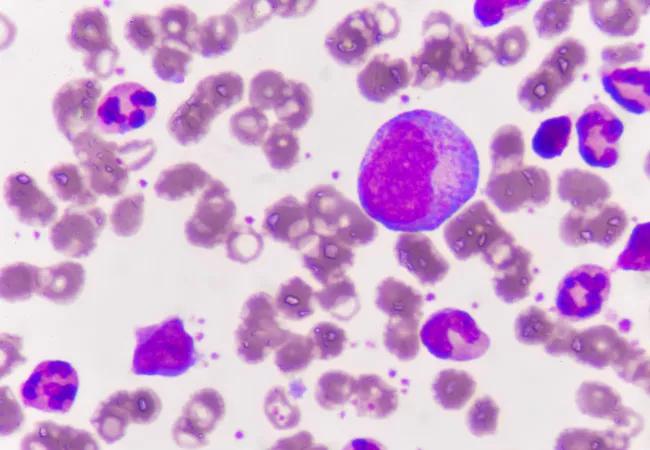

Mutational pattern in MDS is not random, study finds
Image content: This image is available to view online.
View image online (https://assets.clevelandclinic.org/transform/8a31751c-15b9-48d5-898a-5bc4639f12e1/leukemia_650x450_jpg)
leukemia_650x450
For decades, the gold standard of leukemia diagnosis has been cell morphology, or the visual analysis of cellular features to define the disease. Now new discoveries about the sequence of genetic mutations that lead to the cancer’s progression could open the door to a new generation of genetics-based diagnosis — one that could give clinicians unprecedented precision in selecting treatment and predicting outcomes.
Advertisement
Cleveland Clinic is a non-profit academic medical center. Advertising on our site helps support our mission. We do not endorse non-Cleveland Clinic products or services. Policy
A study published last year in Nature Communications builds on more than a decade of research into the genetics of myelodysplastic syndromes (MDS), a collection of preleukemic diseases that primarily affect older adults, at Cleveland Clinic. Earlier studies focused on identifying the mutations that help determine whether a strain of MDS progresses into acute leukemia, or if it remains a manageable chronic condition. Later, researchers worked to catalogue those mutations and understand how they affect clinical outcomes or diagnosis.
“Now we are in a period where we and others are defining the clonal architecture and understanding the succession of molecular lesions that were acquired by the leukemia-initiating cell in order to produce a mature, fully evolved disease,” says Jaroslaw P. Maciejewski, MD, PhD, Chair of the Department of Translational Hematology and Oncology Research at Cleveland Clinic Cancer Center, and coauthor on the study. “This article shows that this is not just a combination of many mutations, but a succession of how they were acquired, with a particular role being assigned to the original, initiating event.”
The breakthrough finding of the new study is that the mutational pattern “is not random,” Dr. Maciejewski says. “The initial hit defines subsequent groups of diseases of leukemia, which each follow their own path, depending on what the second or third hit is.”
While each patient may see many different mutations, and some of those mutations may overlap, the first mutation is the one that defines which type of leukemia will develop and what path the disease will take.
Advertisement
“These lesions are not acquired at once, but they are acquired in a certain hierarchy. There is an initiation lesion, and that is followed by other mutations, and these are followed again by further mutations. And the more you acquire, the more aggressive the disease can be,” he says. “Yet it’s the first lesion that determines, on a molecular level, what type of leukemia it’s going to be.”
The course of the cancer is not completely predetermined by the first mutation, he notes, but the initial hit predisposes leukemia cells to the types of mutations that will follow.
In traditional hematology, morphological evaluation has been the foundation of disease classification, Dr. Maciejewski says, but this method of diagnosis is highly subjective. “Two different mechanisms of leukemia can produce leukemia that looks similar, and for this reason, pathologists would group them as one subentity,” he says. Yet if the two diseases were triggered by different initiating mutations, they could respond differently to traditional treatments, be candidates for certain targeted agents and have different prognoses.
“It is like looking at two red cars, and saying, ‘Both cars are red,’ but one is a Ferrari and one is a Yugo,” he says.
Including genetic criteria, especially the clonal architecture, in leukemia classification will allow pathologists to identify the type of cancer being treated at a molecular level. This will allow clinicians to select certain drugs and avoid others based on disease type and make a more accurate prognosis for the course of the disease.
Advertisement
The next step for the research will be to study differences between the molecular subtypes within leukemia families — groups of diseases defined by a common first mutation — and testing for differences in response to currently available therapies. “The more far-reaching goal is to eliminate from the leukemia diagnostic any subjectivity, by defining a new gold standard based on molecular defects rather than what the cells look like.”
Ironically, he says, advances in genetic identification could ultimately lead to new methods of hyper-accurate morphological diagnosis. By correlating molecular lesions with morphological features, scientists could use new image-recognition technology to pinpoint visual characteristics that serve as markers for these different genetic variations.
Rather than scrapping pathomorphology altogether in favor of genetic identification, “maybe a combination would be more powerful,” he says.
Advertisement
Advertisement
First full characterization of kidney microbiome unlocks potential to prevent kidney stones
Researchers identify potential path to retaining chemo sensitivity
Large-scale joint study links elevated TMAO blood levels and chronic kidney disease risk over time
Investigators are developing a deep learning model to predict health outcomes in ICUs.
Preclinical work promises large-scale data with minimal bias to inform development of clinical tests
Cleveland Clinic researchers pursue answers on basic science and clinical fronts
Study suggests sex-specific pathways show potential for sex-specific therapeutic approaches
Cleveland Clinic launches Quantum Innovation Catalyzer Program to help start-up companies access advanced research technology